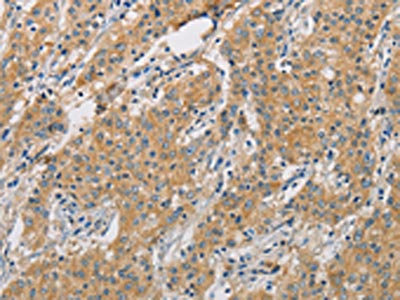

-
中文名稱:ARHGEF7兔多克隆抗體
-
貨號:CSB-PA600132
-
規格:¥1100
-
圖片:
-
The image on the left is immunohistochemistry of paraffin-embedded Human thyroid cancer tissue using CSB-PA600132(ARHGEF7 Antibody) at dilution 1/40, on the right is treated with fusion protein. (Original magnification: ×200)
-
The image on the left is immunohistochemistry of paraffin-embedded Human gastric cancer tissue using CSB-PA600132(ARHGEF7 Antibody) at dilution 1/40, on the right is treated with fusion protein. (Original magnification: ×200)
-
Gel: 8%SDS-PAGE, Lysate: 40 μg, Lane: A172 cells, Primary antibody: CSB-PA600132(ARHGEF7 Antibody) at dilution 1/800, Secondary antibody: Goat anti rabbit IgG at 1/8000 dilution, Exposure time: 3 minutes
-
-
其他:
產品詳情
-
Uniprot No.:
-
基因名:
-
別名:ARHG7 antibody; ARHG7_HUMAN antibody; ARHGEF 7 antibody; Arhgef7 antibody; Beta pix antibody; Beta-Pix antibody; betaPix antibody; betaPix-b antibody; betaPix-c antibody; Cool antibody; COOL-1 antibody; COOL1 antibody; DKFZp686C12170 antibody; DKFZp761K1021 antibody; KIAA0142 antibody; KIAA0412 antibody; mKIAA0142 antibody; Nbla10314 antibody; P50 antibody; P50BP antibody; p85 antibody; P85COOL1 antibody; P85SPR antibody; PAK interacting exchange factor beta antibody; PAK-interacting exchange factor beta antibody; PAK3 antibody; Pak3bp antibody; PIX antibody; PIXB antibody; Rho guanine nucleotide exchange factor (GEF) 7 antibody; Rho guanine nucleotide exchange factor (GEF) 7b antibody; Rho guanine nucleotide exchange factor (GEF7) antibody; Rho guanine nucleotide exchange factor 7 antibody; SH3 domain containing proline rich protein antibody
-
宿主:Rabbit
-
反應種屬:Human,Mouse,Rat
-
免疫原:Fusion protein of Human ARHGEF7
-
免疫原種屬:Homo sapiens (Human)
-
標記方式:Non-conjugated
-
抗體亞型:IgG
-
純化方式:Antigen affinity purification
-
濃度:It differs from different batches. Please contact us to confirm it.
-
保存緩沖液:-20°C, pH7.4 PBS, 0.05% NaN3, 40% Glycerol
-
產品提供形式:Liquid
-
應用范圍:ELISA,WB,IHC
-
推薦稀釋比:
Application Recommended Dilution ELISA 1:2000-1:5000 WB 1:500-1:2000 IHC 1:50-1:200 -
Protocols:
-
儲存條件:Upon receipt, store at -20°C or -80°C. Avoid repeated freeze.
-
貨期:Basically, we can dispatch the products out in 1-3 working days after receiving your orders. Delivery time maybe differs from different purchasing way or location, please kindly consult your local distributors for specific delivery time.
-
用途:For Research Use Only. Not for use in diagnostic or therapeutic procedures.
相關產品
靶點詳情
-
功能:Acts as a RAC1 guanine nucleotide exchange factor (GEF) and can induce membrane ruffling. Functions in cell migration, attachment and cell spreading. Promotes targeting of RAC1 to focal adhesions. May function as a positive regulator of apoptosis. Downstream of NMDA receptors and CaMKK-CaMK1 signaling cascade, promotes the formation of spines and synapses in hippocampal neurons.
-
基因功能參考文獻:
- Traction forces generated by beta-PIX knockdown cells are increased relative to those in control cells, a result consistent with an unexpected enhancement in the migration of single beta-PIX knockdown cells and monolayers of such cells. Authors propose that targeting beta-PIX might be a means of promoting epithelialization of wounds in vivo. PMID: 28596238
- S340E mutation enhances Nox1 activation (Kaito et al., 2014), the present study suggests that betaPix can also play an inhibitory role in O2(-) production, depending on the sites of phosphorylation. PMID: 29242061
- Data suggest that Scribble PDZ-domain-1 and PDZ-domain-3 are major domains that interact with beta-PIX and exhibit distinct binding hierarchy in interactions between individual Scribble PDZ domains and beta-PIX. (Scribble = scribbled planar cell polarity protein; beta-PIX = Rho guanine nucleotide exchange factor 7) PMID: 29061852
- each mutation in LRRK2 and ARHGEF7 demonstrated its unique functional property, which may contribute to the pathogenesis of Parkinson disease PMID: 27423549
- we discuss recent findings in key physiological systems that exemplify current understanding of the function of this important regulatory complex. Further, we draw attention to gaps in crucial information that remain to be filled to allow a better understanding of the many roles of the GIT-PIX complex in health and disease PMID: 27182061
- Data show association of G protein-coupled receptor kinase-interacting protein 1 (GIT1), p21-activated kinase interacting exchange factor (betaPIX), and p21 protein (Cdc42/Rac)-activated kinase 1 (PAK1) with centrosomes. PMID: 27012601
- Data show the role of Rho guanine nucleotide exchange factor 7 (beta-PIX) to the regulation of high mobility of lung adenocarcinoma cell line H1299 via regulation of focal adhesions dynamics, changes in actin cytoskeleton organization and cell polarity. PMID: 25683605
- Phosphorylation of LRRK2 by casein kinase 1alpha regulates trans-Golgi clustering via differential interaction with ARHGEF7. PMID: 25500533
- GIT1/betaPIX/Rac1/PAK pathway plays a crucial role in regulating GABA(A)R synaptic stability and hence inhibitory synaptic transmission with important implications for inhibitory plasticity and information processing in the brain. PMID: 25284783
- Conversely, increased expression of betaPIX in breast cancer cell lines re-couples the Hippo kinase cassette to Yap/Taz, promoting localization of Yap/Taz to the cytoplasm and inhibiting cell migration and proliferation. PMID: 25425573
- Data indicate that suppression of c-Cbl protein by rho guanine nucleotide exchange factor 7 (Cool-1) may be critical for generation of at least a subset of glioblastoma (GBM). PMID: 24458840
- The interaction of betaPix with srGAP1 is critical for maintaining suppressive crosstalk between Cdc42 and RhoA during 3D collagen migration. PMID: 25150978
- BetaPix phosphorylation at Ser-340 upregulates Nox1 through Rac activation. PMID: 24792722
- It has identified and characterized a novel interaction between CaM and beta-p21-activated kinase interacting exchange factor (beta-PIX), a putative guanine exchange factor implicated in cell signaling. PMID: 22588125
- Inhibition of glycogen synthase kinase (GSK)-3beta increases the migration capacity of mesenchymal stromal cells during ex vivo expansion. PMID: 23288365
- beta1Pix functions as a transcriptional regulator of beta-catenin signaling through direct interaction with beta-catenin, an action that may be functionally relevant to colon cancer biology. PMID: 24129564
- BETA-PIX is a novel downstream signalling mediator during invadopodia formation. PMID: 23740575
- In vivo migratory capacity of mesenchymal stromal cells depends upon the expression level of beta-PIX. PMID: 22087847
- These defects could be rescued by depletion of ARHGEF7 and p21-activated kinase, Rac1-specific effector proteins required for cell adhesion. PMID: 22945935
- a model by which SNX27 regulates trafficking of beta-Pix to focal adhesions and thereby influences cell motility. PMID: 21926430
- Results describe the role of beta-Pix in the negative regulation of focal adhesion maturation and the promotion of lamellipodial protrusion and focal adhesion turnover to drive cell migration. PMID: 21423176
- Downstream effects of phosphorylation of ARHGEF7 through LRRK2 could be (i) a feedback control mechanism for LRRK2 activity as well as (ii) an impact of LRRK2 on actin cytoskeleton regulation PMID: 21048939
- betaPix up-regulates NHE3 membrane expression and activity by Shank2-mediated protein-protein interaction and by activating Rho GTPases in the apical regions of epithelial cells PMID: 20080968
- MYO18A is a novel binding partner of the PAK2/betaPIX/GIT1 complex and suggest that MYO18A may play an important role in regulating epithelial cell migration via affecting multiple cell machineries. PMID: 19923322
- bFGF- and NGF-induced phosphorylation of p85 betaPIX mediates Rac1 activation, which in turn regulates cytoskeletal reorganization at growth cones, but not translocation of the PIX complex. PMID: 14557270
- PIX protein is tightly associated with the GIT family ARF GTPase-activating proteins as a multimeric nexus capable of linking together important signaling molecules. PMID: 15212761
- PAK1 recruitment to the T cell-antigen-presenting cell interface required interaction with PIX. PMID: 15864311
- These results suggest that the formation of the complex consisting of Nox1, betaPix, and NoxO1 is likely to be a critical step in EGF-induced ROS generation. PMID: 16329988
- the SH3 domain of betaPix specifically interacts with a proline-arginine motif (PxxxPR) present within the ubiquitin ligase Cbl and Pak1 kinase. Cdc42/betaPix complex blocks Cbl's ability to downregulate EGFR. PMID: 16407834
- Rac1-beta-Pix interaction is required for Rac1 activation by beta-Pix as well as for Rac1-mediated spreading PMID: 16492808
- These data strongly suggest that, in addition to the known SAP-interacting kinase Fyn, PIX may be another key player in SAP-mediated T cell activation. PMID: 16983070
- Tiam1 and betaPIX mediate OxPAPC-induced Rac activation, cytoskeletal remodeling, and barrier protective response in pulmonary endothelium PMID: 17219408
- The association of PLCgamma1 with complexes containing GIT1 and beta-Pix is essential for its role in integrin-mediated cell spreading and motility. As a component of this complex, PLCgamma1 is also involved in the activation of Cdc42 and Rac1. PMID: 17562871
- PKA-dependent phosphorylation modulates PIXB activity through 14-3-3-beta binding. PMID: 18160719
- mutant betaPIX lacking guanine nucleotide exchange factor activity inhibited lamellipodium formation PMID: 18325335
- These results identify p66Shc and FOXO3a as novel partners of beta(1)Pix and represent the first direct evidence of beta(1)Pix in cell proliferation via Erk/p66Shc-dependent and Akt-independent mechanisms. PMID: 18385518
- Data show that the Rac1 guanine exchange factor- beta-Pix, localizes to focal contacts in human primary Schwannoma cells. PMID: 18445079
- Beta-PIX regulates nitric oxide synthase type 2 (NOD2) trafficking and NOD2-dependent signal transduction in primary human monocytes and cell line THP-1. PMID: 18684957
- betaPIX and GIT1 regulate the hepatocyte growth factor-induced and Rac1-dependent membrane transport of WAVE2 and consequently, lamellipodia formation. PMID: 19303398
顯示更多
收起更多
-
亞細胞定位:Cell junction, focal adhesion. Cell projection, ruffle. Cytoplasm, cell cortex. Cell projection, lamellipodium. Note=Detected at cell adhesions. A small proportion is detected at focal adhesions.
-
數據庫鏈接:
Most popular with customers
-
-
YWHAB Recombinant Monoclonal Antibody
Applications: ELISA, WB, IHC, IF, FC
Species Reactivity: Human, Mouse, Rat
-
Phospho-YAP1 (S127) Recombinant Monoclonal Antibody
Applications: ELISA, WB, IHC
Species Reactivity: Human
-
-
-
-
-